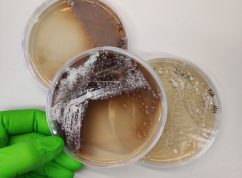
Mikroorganismy MENDELU

Vědkyně z Agronomické fakulty MENDELU v Brně Stanislava Bezdíček Králová na Antarktidě zkoumá, jakým způsobem tamní mikroorganismy produkují bioaktivní peptidy. Při výzkumu chce také zjistit, jak jsou tyto látky specifické pro antarktické prostředí a jak se pozmění, aby v extrémních podmínkách fungovaly. Výzkum probíhá na ostrově Jamese Rosse pod záštitou Českého antarktického výzkumného programu Masarykovy univerzity, informovala mluvčí Mendelovy univerzity Tereza Pospíchalová.
Polárního výzkumu se Stanislava Bezdíček Králová zúčastnila již v minulosti. Před pěti lety odebírala na Antarktidě vzorky ke kultivaci bakterií. Letos se však na ledovém kontinentu zaměří na výzkum environmentální DNA mikroorganismů, které v extrémních podmínkách přežívají. „Cílem je pochopit, jakým způsobem antarktické bakterie produkují bioaktivní peptidy a zda jsou tyto peptidy specifické pro antarktické prostředí. Budeme také zkoumat, jak jsou pozměněné, aby v daných abiotických podmínkách dokázaly fungovat,“ vysvětlila vědkyně.
Bioaktivní peptidy jsou antimikrobiální a antikarcinogenní látky, jejich využití ale může být mnohem širší
„Mohou fungovat i jako antifugální látky a najít své využití třeba v ochranných postřicích,“ řekla Bezdíček Králová. Kromě peptidové chemie se vědkyně zaměří i na enzymologii. „K tomu, aby peptidy vznikly, jsou zapotřebí specifické enzymy, a i mohou být pozměněny, aby fungovaly v antarktických podmínkách. Potenciálně by se tyto enzymy daly využít i v chladových podmínkách u nás,“ dodala výzkumnice.
Hlavním úkolem bude izolovat takzvanou environmentální DNA
Ta v sobě nese informace o evoluci zmíněných látek. „Ideální by bylo vzorky, ze kterých DNA odebíráme, usušit na místě a v tomto stavu je dovézt. Bohužel ale nemáme lyofilizátor, který by dokázal na výzkumné stanici dlouhodobě fungovat. Vzorky proto zmrazíme, a takto zmražené je dopravíme až do laboratoří, kde je teprve usušíme a budeme s nimi dále pracovat,“ popsala proces Bezdíček Králová.
Na Antarktidě momentálně panuje antarktické léto a podmínky pro výzkum jsou tak nejvhodnější
Standardně jsou tam nyní teploty mezi 0 ±10 °C. Mikroorganismy zde však během roku přežívají v extrémních mrazech. „Teploty zde klesají k -30 °C a hlouběji. Nyní při oteplení se bakterie rozehřejí, nastartuje se na nějakou dobu jejich metabolismus, ale poté znovu zmrznou. Opakování těchto cyklů je to nejhorší, co může živá buňka přežít. To, že bakterie na Antarktidě takto přežívají, je jedna z nejvíce fascinujících věcí v biologii,“ popsala proces přežívání vědkyně.
Získání informací z environmentální DNA pomůže vědcům pochopit, jak funguje chladová chemie bakterií na Antarktidě
„Poznání těchto procesů se dá aplikovat při likvidaci určitých patogenů nebo v chemii, která bude aktivní pouze v nízkých teplotách. Z dovezeného permafrostu a jeho aktivní vrstvy budeme v Česku izolovat DNA, kolegové z Fakultní nemocnice v Brně ji sekvencují a ve spolupráci s týmem VUT Brno následně datovou informaci zpracujeme a budeme hledat konkrétní zákonitosti,“ přiblížila Bezdíček Králová. Genetickou informaci antarktických mikroorganismů bude vědecký tým takto zkoumat poprvé.